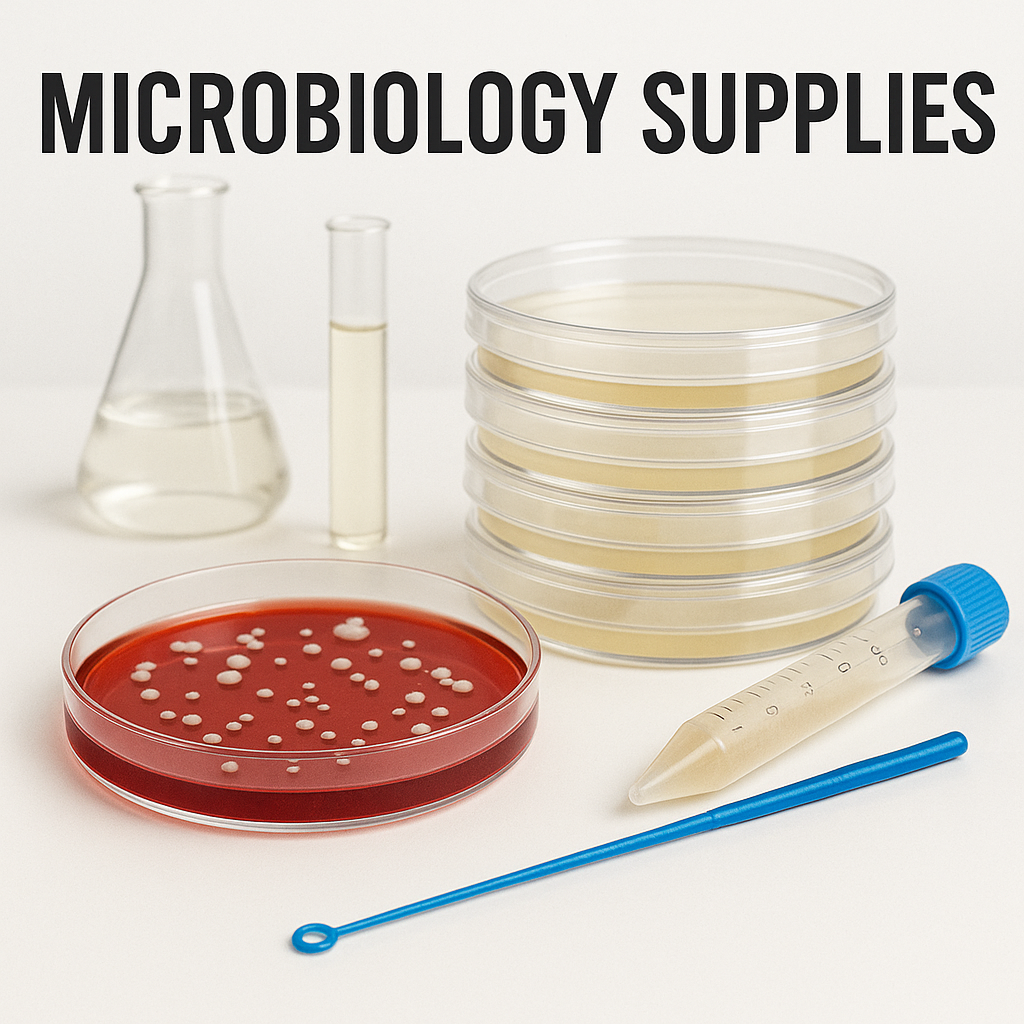

-
Pick Me!

Hardy Diagnostics
Hardy Diagnostics Tryptic Soy Agar (TSA), USP 10/pack
Retail Price $22.50Our Price! $14.64 -
Pick Me!

-
Pick Me!

-
Pick Me!

-
Pick Me!

Hardy Diagnostics
Hardy Diagnostics Potato Dextrose Agar (PDA) with Tartaric Acid (TA), 10/pk
$31.23 -
Pick Me!

-
Pick Me!

Nelson-Jameson
3M Petrifilm Rapid Yeast & Mold (RYM) Count Plates 6477, 500 each/case
Retail Price $1,737.83Our Price! $1,386.82 -
Pick Me!
FilterMAX
FilterMAX MCE Membrane Filter, White, 47mm, 0.45um, NON-STERILE, case of 1000 (10 packs of 100)
Retail Price $821.24Our Price! $513.27 -
Pick Me!

Nelson-Jameson
3M Petrifilm Aerobic Count (AC) Plates 6406, 1000 each/case
Retail Price $1,444.55Our Price! $1,094.21 -
Pick Me!

Nelson-Jameson
3M Petrifilm E. coli/ Coliform (EC) Count Plates 6414, 500 each/case (20 packs of 25)
Retail Price $1,700.00Our Price! $1,300.48 -
Pick Me!

Hardy Diagnostics
Hardy Diagnostics Blood Agar Plate, 5% Sheep Blood in Tryptic Soy Agar (TSA) Base, case of 100
$125.84 -
Pick Me!

Nelson-Jameson
3M Petrifilm Rapid Coliform Count (RCC) Plates 6412, 500 each/case
Retail Price $1,620.29Our Price! $1,246.38 -
Pick Me!

FilterMAX
FilterMAX MCE Gridded Membrane Filter, White, 47mm, 0.45um, STERILE, INDIV. WRAPPED, case of 1000 (10 packs of 100)
Retail Price $1,107.03Our Price! $691.90 -
Pick Me!

Nelson-Jameson
3M Petrifilm Rapid Aerobic Count (RAC) Plates 6479, case of 500 (20 packs of 25)
Retail Price $1,356.19Our Price! $1,154.22 -
Pick Me!

Nelson-Jameson
3M Petrifilm Rapid E.coli / Coliform Count (REC) Plate 6437, case of 500
Retail Price $1,789.42Our Price! $1,394.36 -

-
Pick Me!

Nelson-Jameson
3M Petrifilm Salmonella Express (SALX) Plate 6537, 200 per case
Retail Price $1,514.12Our Price! $1,164.71 -
Pick Me!

Nelson-Jameson
3M Petrifilm Enterobacteriaceae (EB) Count Plates 6421, 1000 each/case
Retail Price $1,670.59Our Price! $1,297.18 -
Pick Me!

Nelson-Jameson
3M Petrifilm Lactic Acid Bacteria Count Plates 6462, 1000 each/case
Retail Price $1,376.65Our Price! $1,146.21 -
Pick Me!

Hardy Diagnostics
CRITERION Brilliant Green Agar, Modified, Dehydrated Culture Media, 500gm Wide-Mouth Bottle
$134.00
Microbiology Supplies


